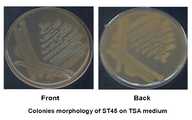

본 발명은 식물의 생장을 촉진하는 미생물 제제에 관한 것이다.The present invention relates to a microbial agent for promoting plant growth.
식물은 생장하면서 다양한 환경 스트레스에 노출되며, 이러한 스트레스는 식물의 생장, 발달, 생산성 등에 영향을 미친다. 스트레스에는 다른 생물체에 의해 일어나는 생물학적(biotic) 스트레스와 물리학적 또는 화학적 환경의 변화에 의해 일어나는 非생물학적(abiotic) 스트레스가 있다. 식물의 스트레스에 대한 저항성 작용은 일반적으로 스트레스에 노출되는 것을 방지하는 '회피작용'과 스트레스를 견디는 '내성작용'으로 나눌 수 있으며, 내성작용을 갖더라도 식물체가 견딜수 있는 이상의 환경 스트레스에 대해서는 식물의 생육과 성장의 질에 영향을 미친다. 건조 스트레스시 식물의 광합성이 제한되어 과도한 광에 노출되면 광합성 반응중심이 과도하게 환원되어 광계2가 파괴되며 엽록체에는 활성산소종의 생성이 증가한 다. Na+와 Cl-의 농도가 원인이 되어 염해가 발생하면 수화적(hydration) 삼투작용 이상으로 인한 스트레스를 나타내어 결국은 식물을 죽게 한다. 염해를 받은 식물은 생장이 감소하고 세포분열(cell division)과 팽창(expansion)이 억제되며 괴사를 촉진한다. 또한 막해체(membrane disorganization), 활성산소종, 대사독성(metabolic toxicity), 광합성 억제 등의 효과를 나타낸다. 화학비료를 오래 사용하면 염류가 축적되면서 제대로 작물에 흡수되지 못하고 토양의 염류농도 및 산성화 증가, 생산력 감퇴, 작물수량의 감소 및 품질 저하를 초래한다. 식물체가 기계적인 경미한 스트레스나 환경으로부터의 심한 스트레스를 받을 경우 공통으로 일어나는 막 기능의 상실과 함께 에틸렌 생성이 급격히 증가하는 현상이 발생한다. 이러한 에틸렌은 식물체의 정상적인 생장, 발생과정에서 생성되는 에틸렌과 구분하여, 특별히 스트레스-에틸렌이라고 부른다. 식물체가 환경으로부터 스트레스를 받게 되면 공통으로 식물체의 에틸렌 생합성이 증가하게 된다. 예를 들어 식물체가 병원체의 침범을 받은 직후에 에틸렌의 생성량은 급격히 증가하고, UV-B를 배(Pyruscommunis L.)의 줄기에 조사할 경우에도 에틸렌 생성량은 급격히 증가한다.As plants grow, they are exposed to a variety of environmental stresses, which affect plant growth, development, and productivity. Stress includes biological stress caused by other organisms and abiotic stress caused by changes in the physical or chemical environment. The resistance of plants to stress is generally divided into 'avoidance' to prevent exposure to stress and 'tolerance' to withstand stress. It affects the quality of growth and growth. When photosynthesis of plants is limited during dry stress and exposed to excessive light, photosynthetic reaction center is excessively reduced and
식물체 내에서 에틸렌의 생합성은 메티오닌이 SAM 합성효소(S-adenosyl-methionine synthase)에 의해서 SAM으로 변환되고, 변환된 SAM이 ACC 합성효소(1-aminocyclopropane-1-carboxylate synthase)에 의해 ACC로 변환되며 최종적으로 ACC 산화효소(ACC oxidase)에 의해 에틸렌을 생성하는 비교적 단순한 경로를 거쳐 서 생합성 된다. 일반적으로 에틸렌 생합성 과정에서 흐름을 조절하는데 가장 중요한 율속단계(rate-limiting step)는 ACC 합성효소에 의해 SAM에서 ACC로 변환되는 과정이다. 서로 다른 몇 종류의 ACC 합성효소 유전자들이 각각 다른 내적, 외적 요인들에 반응하여 전사 촉진되며, 결과적으로 ACC 합성효소의 활성이 증가하여 식물체 내의 ACC 농도는 높아지게 된다. 이렇게 생성된 ACC는 높은 입체특이성이 있으며, 활성을 위하여 아스코르브산염(ascorbate)과 Fe2+를 필요로 하는 ACC 산화효소(일명 에틸렌 형성 효소)에 의하여 에틸렌으로 전환된다. 그러므로 정상적인 식물체 내에서의 에틸렌 생합성은 ACC 합성효소와 ACC 산화효소의 유도, 및 그들의 활성에 의하여 조절될 수 있다. 접촉이나 경미한 기계적 스트레스에 의하여 유도되는 일부 스트레스-에틸렌은 스트레스에 의하여 전사, 촉진된 ACC 합성효소에 의하여 식물체 내의 ACC 양이 증가하게 되고, 스트레스에 의하여 활성이 촉진되거나 또는 스트레스 여부와는 상관없이 활성이 항상 유지되고 있는 ACC 산화효소에 의하여 생합성 된다. 하지만 이렇게 생성된 스트레스-에틸렌은 조절 가능하다.The biosynthesis of ethylene in plants is that methionine is converted to SAM by S-adenosyl-methionine synthase, and the converted SAM is converted to ACC by ACC synthase (1-aminocyclopropane-1-carboxylate synthase). Finally, they are biosynthesized via a relatively simple pathway to produce ethylene by ACC oxidase. In general, the most important rate-limiting step in regulating flow in ethylene biosynthesis is the conversion of SAM to ACC by ACC synthase. Several different types of ACC synthase genes are transcriptionally promoted in response to different internal and external factors. As a result, the activity of ACC synthase increases, resulting in higher ACC concentrations in plants. The generated ACC has a high stereospecificity, is converted to ethylene by ascorbate (ascorbate) and ACC oxidase (also known as ethylene forming enzyme) that requires a Fe2+ for activity. Therefore, ethylene biosynthesis in normal plants can be regulated by the induction of ACC synthase and ACC oxidase, and their activity. Some stress-ethylene, induced by contact or mild mechanical stress, increases the amount of ACC in the plant by ACC synthase, which is transcribed and promoted by stress, and is active regardless of whether or not stress is promoted. It is biosynthesized by ACC oxidase which is always maintained. However, the stress-ethylene thus produced is controllable.
에틸렌가스는 식물 내에서 호르몬의 일종으로서 식물의 성숙을 촉진하는데, 대표적인 예로 과실의 숙도, 씨앗의 발아, 유묘(어린 모종) 생장, 잎과 꽃잎의 이탈, 기관 노화, 스트레스, 병원성에 대한 반응 등 식물의 전 생활사에 있어서도 중요한 역할을 담당하고 있는 것으로 알려져 있다. 에틸렌은 식물 종과 세포 타입에 의존적으로 생장을 촉진하기도 하고 저해시키기도 하는 것으로 알려져 있는데, 저수위의 에틸렌은 뿌리 신장을 촉진하고 뿌리의 빠른 생장에 영향을 미치지만, 고수 위의 에틸렌은 오히려 뿌리 신장을 억제하는 것으로 밝혀진 바 있다. 식물이 스트레스를 받으면 에틸렌 생합성에 의해 에틸렌의 전구체인 ACC의 생성량이 증가하고 이로 인해 식물체내의 에틸렌 농도가 높아져 식물 생장을 저해한다. 스트레스를 받은 식물에 ACC는 ACC 탈아미노효소(ACC deaminase)를 처리한 경우에, ACC가 가수분해되어 스트레스 에틸렌의 생성농도가 낮아져 식물생장에 긍정적인 영향을 미치는 것으로 보고된바 있다(Penrose DM & Glick BR,Can JMicrobiol 47:368-372, 2001). 또한, ACC 탈아미노효소를 생성하는 PGPB(plant growth promoting bacteria)를 처리한 식물체에 ACC를 처리하자 스트레스 에틸렌의 생성량이 무처리군에 비해 적게 나타났었다(Glick BRetal., JTheorBiol 190:63-68, 1998). 아울러, 근권 미생물로부터 생성되는 고농도의 IAA(indole acetic acid)에 의해 무화과 나무에서 ACC가 생성되고, 이렇게 생성된 식물 내부의 ACC는 외부로 배출되어 외부와의 균형을 맞춰 유지된다. 이때, 외부에서 연속적으로 PGPB에 의해 ACC가 가수분해되면 식물내 ACC 생성량이 줄어들어서, 스트레스 에틸렌의 생합성량은 줄어들게 되는 것으로 보고된바 있다(Arshd M et al.,TrendsinBiotechnol. 25:356-362, 2007)Ethylene gas is a hormone in plants that promotes the maturation of plants. Typical examples include fruit ripening, seed germination, seedling growth, leaves and petals leaving, organ aging, stress, and response to pathogenicity. It is known to play an important role in the whole life history of plants. Ethylene is known to promote and inhibit growth depending on plant species and cell type. Low-level ethylene promotes root elongation and affects rapid growth of roots, whereas high-level ethylene does not promote root elongation. It has been found to inhibit. When plants are stressed, ethylene biosynthesis increases the amount of ACC that is a precursor of ethylene, which increases the concentration of ethylene in the plant, thereby inhibiting plant growth. When ACC is treated with ACC deaminase in stressed plants, it has been reported that ACC is hydrolyzed to lower the production of stress ethylene, which has a positive effect on plant growth (Penrose DM & Glick BR,CanJMicrobiol 47: 368-372, 2001). In addition, when ACC was treated to plants treated with plant growth promoting bacteria (PGPB) that produced ACC deaminoase, stress ethylene was produced less than that of the untreated group (Glick BRet.al. ,JTheorBiol 190: 63-68, 1998). In addition, ACC is generated from the fig tree by a high concentration of indole acetic acid (IAA) generated from the root zone microorganisms, and the ACC inside the plant is discharged to the outside to maintain balance with the outside. At this time, when ACC is hydrolyzed continuously by PGPB from outside, it is reported that the amount of ACC produced in plants decreases, thereby reducing the biosynthesis of stress ethylene (Arshd M et al.,TrendsinBiotechnol. 25: 356-362, 2007)
이에, 본 발명자들은 토양시료로부터 분리한 신규 엔테로박터 sp. ST45 균주(KCTC 11528BP) 및 ST502 균주(KCTC 11532BP)가 ACC 탈아미노화 효소 활성을 갖고, 식물의 생장을 촉진하여, 식물 생장 촉진용 미생물 제제로 사용될 수 있음을 확인함으로써 본 발명을 완성하였다.Thus, the present inventors have isolated a novel Enterobacter sp. The present invention was completed by confirming that the ST45 strain (KCTC 11528BP) and the ST502 strain (KCTC 11532BP) have ACC deamination enzyme activity, promote plant growth, and can be used as a microbial agent for promoting plant growth.
본 발명의 목적은 ACC(1-aminocyclopropane-1-carboxylate synthase) 탈아미노화 효소 활성을 갖고, 스트레스에 대한 내성을 갖는, 식물의 생장을 촉진하는 신 균주를 제공하는 것이다.It is an object of the present invention to provide a new strain that promotes plant growth, which has ACC (1-aminocyclopropane-1-carboxylate synthase) deaminoase activity and is resistant to stress.
본 발명의 다른 목적은 상기 균주 또는 이의 배양액을 유효성분으로 포함하는 미생물 제제 및 이의 제조방법을 제공하는 것이다.Another object of the present invention is to provide a microbial agent and a method for producing the same comprising the strain or its culture as an active ingredient.
본 발명의 다른 목적은 상기 균주, 이의 배양액 또는 상기 미생물 제제를 이용한 식물생육 촉진방법 또는 식물의 스트레스에 대한 저항성을 증진하는 방법을 제공하는 것이다.Another object of the present invention is to provide a method for promoting plant growth using the strain, its culture medium or the microbial agent, or a method for enhancing resistance to stress of plants.
상기 목적을 달성하기 위하여, 본 발명은 ACC(1-aminocyclopropane-1-carboxylate synthase) 탈아미노화 효소 활성을 갖고, 스트레스에 대한 내성을 갖는, 식물의 생장을 촉진하는 엔테로박터 sp. ST45 균주(KCTC 11528BP) 및 ST502(KCTC 11532BP)를 제공한다.In order to achieve the above object, the present invention has a 1-aminocyclopropane-1-carboxylate synthase (ACC) deaminolase activity, has resistance to stress, enterobacter sp. ST45 strain (KCTC 11528BP) and ST502 (KCTC 11532BP) are provided.
또한, 본 발명은 상기 균주 또는 이의 배양액을 유효성분으로 포함하는 미생물 제제를 제공한다.The present invention also provides a microbial agent comprising the strain or its culture as an active ingredient.
또한, 본 발명은 상기 균주를 배양하여 미생물 제제를 제조하는 방법을 제공한다.The present invention also provides a method for preparing a microbial agent by culturing the strain.
또한, 본 발명은 상기 균주, 이의 배양액 또는 상기 미생물 제제를 토양, 식물 또는 식물의 종자에 처리하는 단계를 포함하는 식물생육 촉진방법을 제공한다.In addition, the present invention provides a method for promoting plant growth, comprising the step of treating the strain, its culture or the microbial agent to soil, plants or seeds of plants.
아울러, 본 발명은 상기 균주, 이의 배양액 또는 상기 미생물 제제를 토양, 식물 또는 식물의 종자에 처리하는 단계를 포함하는 식물의 스트레스에 대한 저항성을 증진하는 방법을 제공한다.In addition, the present invention provides a method of enhancing resistance to stress of a plant, comprising the step of treating the strain, its culture or the microbial agent to soil, a plant or a seed of a plant.
이하, 본 발명을 상세히 설명한다.Hereinafter, the present invention will be described in detail.
본 발명은 ACC(1-aminocyclopropane-1-carboxylate synthase) 탈아미노화 효소 활성을 갖고, 스트레스에 대한 내성을 갖는, 식물의 생장을 촉진하는 엔테로박터 sp. ST45 균주(KCTC 11528BP) 및 ST502(KCTC 11532BP)를 제공한다.The present invention has a 1-aminocyclopropane-1-carboxylate synthase (ACC) deaminolase activity, resistant to stress, enterobacter sp. ST45 strain (KCTC 11528BP) and ST502 (KCTC 11532BP) are provided.
전 세계적으로 이용 적합한 용수의 부족과 사막화로 인한 작물생산 가능 농지의 축소로 작물의 생장에 적합한 환경이 점점 줄어드는 실정이다. 작물에 이러한 생물학적, 비생물학적 환경으로부터 스트레스가 가해지면, 작물 내 스트레스 에틸렌 생성이 급격히 증가하여 작물의 생산성을 떨어뜨리는 부정적인 영향을 미친다. 이러한 스트레스 에틸렌을 줄일 수 있는 ACC 탈아미노화 효소를 생성하는 균주들을 토양시료로부터 스크리닝하였고(도 1 참조), ACC 탈아미노화 효소 활성값이 61 내지 80 구간이고, 재현성이 높으며, 16S rDNA 염기서열의 유사도가 낮은 균주를 선별하여 ST45 및 ST502라고 명명하였고, 이를 한국생명공학연구원 생물자원센터(KCTC)에 2009년 7월 8일 및 7월 21일 일자로 기탁하였으며, 기탁번호는 각각 KCTC 11528BP 및 KCTC 11532BP이다.Due to the shortage of suitable water available worldwide and the reduction of crop production farmland due to desertification, the environment suitable for growing crops is gradually decreasing. When crops are stressed from this biological and non-biological environment, the stress ethylene production in the crops increases dramatically, negatively affecting crop productivity. Strains that produce ACC deaminolase to reduce such stress ethylene were screened from soil samples (see FIG. 1), and ACC deaminolase activity values were 61 to 80 sections, high reproducibility, and 16S rDNA sequences. Strains with low similarity were selected and named as ST45 and ST502, which were deposited with the Korea Institute of Biotechnology and Biotechnology Center (KCTC) on July 8 and July 21, 2009. The accession numbers were KCTC 11528BP and KCTC 11532BP.
상기 ST45 및 ST502는 계통적으로 엔테로박터 속내에서 위치하고 있었고(도 2 참조), 상기 ST45의 16S rDNA는 엔테로박터 캔세로지너스(Enterobacter cancerogenus: 97.1%), 엔테로박터 아스부리애(Enterobacterasburiae: 96.7%) 및 엔테로박터 루드위지(Enterobacterludwigii: 96.7%) 순으로 높은 유사도를 나타내었다. 상기 ST45는 한 가닥의 편모가 있어 운동성을 띄며, 짙은 크림색의 콜로니를 생성하였다(도 3 및 도 4a 참조). 상기 ST502는 편모가 없는 타원형이며, 유백색의 밝은 크림색의 콜로니를 형성하였다(데이타 기재하지 않음).The ST45 and ST502 were systematically located in the enterobacter (see FIG. 2), the 16S rDNA of the ST45 wasEnterobactercancerogenus (97.1%),Enterobacterasburiae (Enterobacterasburiae: 96.7%) and Enterobacter Ruud tea(Enterobacterludwigii : 96.7%) showed the highest similarity. The ST45 has a strand of flagella, exhibiting mobility and producing dark creamy colonies (see FIGS. 3 and 4A). The ST502 was elliptical without flagella, forming a milky white bright creamy colony (data not shown).
또한, ST45의 생육조건은 8% 이상의 염 농도에서 생육이 저하되었고, 28℃-35℃에서 최적 성장을 보였으며, 최적 pH는 5-8이었다(표 3 참조). ST502의 생육조건은 8% 이상의 염 농도에서 생육이 저하되었고, 28℃-35℃에서 최적 성장을 보였으며, 최적 pH는 6-8이었다(표 3 참조).In addition, the growth conditions of the ST45 growth was lowered at the salt concentration of more than 8%, showed the optimum growth at 28 ℃ -35 ℃, the optimum pH was 5-8 (see Table 3). The growth conditions of ST502 showed lower growth at salt concentrations of 8% or higher, optimal growth at 28 ° C-35 ° C, and an optimum pH of 6-8 (see Table 3).
또한, ST45는 에스큘린(esculin)은 가수분해하였고, 탄소원으로는 D-라피노오스(raffinose) 및 D-멜리보우즈(melibiose)를 이용하였으며, 트롤린도마이신(troleandomycin; 100 ㎍/㎖), 리파마이신 5v(rifamycin 5v; 100 ㎍/㎖), 미노싸이클린(minocycline; 100 ㎍/㎖), 밴코마이신(vancomycin; 100 ㎍/㎖)에 대하여 감수성을 보였다. 또한, ST502는 탄소원으로 아도니톨, D-솔비톨, D-자일로오스, 만니톨, 슈크로스, D-라피노오스 및 D-멜리보우즈를 이용하였으며, L-과당은 이용하지 않았다. 또한, TSA 배지에서 8% 이상의 염농도에서 생육이 저하되는 것으로 나타났다. 또한 4℃에서는 성장하지 못하였고 28℃-35℃에서 최적 성장을 보였으 며 45℃ 이상에서는 성장하지 못하거나 더디었다. 최적 pH는 6-8이었다. 아울러, ST45의 DNA G+C 함량도 다른 엔테로박터속 내의 종(52-60몰%)에서 보고된 함량범위 내에 속하였다.In addition, ST45 hydrolyzed esculin, D-raffinose and D-melibiose as a carbon source, troleandomycin (100 ㎍ / ㎖), Sensitivity was shown for rifamycin 5v (100 μg / ml), minocycline (100 μg / ml), and vancomycin (100 μg / ml). In addition, ST502 used adonitol, D-sorbitol, D-xylose, mannitol, sucrose, D-rapinose, and D-meliboose as a carbon source, and did not use L-fructose. It was also shown that growth was lowered at salt concentrations of 8% or higher in TSA medium. Also, it did not grow at 4 ℃, showed optimal growth at 28 ℃ -35 ℃, and did not grow or slowed at above 45 ℃. The optimal pH was 6-8. In addition, the DNA G + C content of ST45 also falls within the reported range of content in species (52-60 mol%) in other Enterobacter genus.
또한, ST45 및 ST502의 세포벽 지방산 조성분석 결과 C16:0, C17:0 cyclo 및 C18:1 ω7c 등이 주요 성분으로 나타나 같은 엔테로박터속의 특성을 보였다(표 5 및 6 참조).In addition, as a result of cell wall fatty acid composition analysis of ST45 and ST502, C16: 0 , C17: 0 cyclo and C18: 1 ω7c were shown as main components, showing the same characteristics of enterobacter (see Tables 5 and 6).
ST45 및 ST502의 ACC 탈아미노화 효소 활성값은 대조균주인 슈도모나스 플로레센스와 비교하여 3~4배 이상 높았고, ST45 및 ST502에서 옥신의 생성수치가 슈도모나스 플로레센스보다 낮았다(도 5 참조). 이것은 ST45 및 ST502가 작물과 협력하여 작물 내의 에틸렌 농도를 조절함으로써 작물의 생장에 긍정적인 영향을 줄 수 있음을 암시하는 것이다. 이를 토마토 묘목으로 포트(Pot) 실험에서 고염 처리 후 확인한 결과, ST45 및 ST502 처리에 의해 고염 스트레스에 대해 내성을 가지며, 식물의 생장촉진에 긍정적인 영향을 주는 것을 확인하였다(도 6 내지 도 8 참조).The ACC deamination enzyme activity values of ST45 and ST502 were 3-4 times higher than those of the control strain Pseudomonas florescens, and the production level of auxin was lower than that of Pseudomonas florescence in ST45 and ST502 (see FIG. 5). This suggests that ST45 and ST502 can work positively on crop growth by controlling the ethylene concentration in the crop in cooperation with the crop. This was confirmed after the high salt treatment in the pot (Pot) experiment with tomato seedlings, it was confirmed that it is resistant to high salt stress by the ST45 and ST502 treatment, and has a positive effect on the growth of the plant (see FIGS. 6 to 8). ).
이에, 본 발명의 ST45 및 ST502 균주는 작물의 생육에 긍정적인 영향을 주기 위해 유용하게 사용될 수 있다.Thus, the ST45 and ST502 strains of the present invention can be usefully used to positively affect the growth of crops.
또한, 본 발명은 상기 균주 또는 이의 배양액을 유효성분으로 포함하는 미생물 제제를 제공한다.The present invention also provides a microbial agent comprising the strain or its culture as an active ingredient.
본 발명의 균주는 고염 스트레스에 대해 내성을 가지며, 작물의 생장을 촉진 하므로 미생물 제제로 이용할 수 있다(도 6 내지 도 8 참조). 상기 미생물 제제는 상기 균주 또는 이의 배양액을 유효성분으로 포함할 수 있다. 본 발명에 의한 미생물 제제는 통상적인 방법으로 식물 생장 촉진용으로 제형화 할 수 있으며 건조분말 형태 또는 액상비료 형태로 제조할 수 있다. 구체적으로, 본 발명에 의한 미생물 제제는 액상 비료 형태로 제조될 수 있으며 이에 증량제를 첨가하여 가루분말의 형태로 이용하거나 이를 제형화하여 과립화시킬 수도 있다. 그러나 그 제형에 특별히 한정되지는 않는다. 바람직하게는 화학비료를 대체하기 위한 식물생장촉진 생물비료로 제형화 할 수 있고, 즉 화학비료 공급이 제한된 친환경 유기농업에서 이를 극복하기 위한 생물비료로 제형화가 가능하다.The strain of the present invention is resistant to high salt stress, and can be used as a microbial agent because it promotes crop growth (see FIGS. 6 to 8). The microbial agent may include the strain or its culture as an active ingredient. Microbial preparations according to the invention can be formulated for promoting plant growth in a conventional manner and can be prepared in the form of dry powder or liquid fertilizer. Specifically, the microbial preparation according to the present invention may be prepared in the form of a liquid fertilizer and may be used in the form of powdered powder by adding an extender thereto or granulated by formulating it. However, the formulation is not particularly limited. Preferably it can be formulated as a plant growth promoting biofertilizer to replace the chemical fertilizer, that is, it can be formulated as a biofertilizer to overcome this in eco-friendly organic farming where the chemical fertilizer supply is limited.
또한, 본 발명은 상기 균주를 배양하여 미생물 제제를 제조하는 방법을 제공한다.The present invention also provides a method for preparing a microbial agent by culturing the strain.
상기 균주는 8% 이상의 염 농도에서 생육이 저하되었고, 30℃-35℃에서 최적 성장을 보였으며, 최적 pH는 5-8이었다(표 3 참조). 또한, 상기 균주는 에스큘린(esculin)과 세린은 가수분해하였고, 탄소원으로는 D-라피노오스(raffinose), D-멜리보우즈(melibiose), D-살리신(salicin), D-만니톨, D-과당을 이용하였다(표 3 참조). 상기 생육 조건에서 배양된 상기 균주는 고염 스트레스에 대해 내성을 가지며, 작물의 생장을 촉진하므로 미생물 제제로 이용할 수 있다(도 6 내지 도 8 참조).The strains showed reduced growth at salt concentrations of 8% or higher, showed optimal growth at 30 ° C-35 ° C, and an optimal pH of 5-8 (see Table 3). In addition, the strain is hydrolyzed esculin (esculin) and serine, D-rapinose (raffinose), D-melibiose, D-salin (D-salin), D-mannitol, D as the carbon source Fructose was used (see Table 3). The strain cultured in the growth conditions is resistant to high salt stress, and can be used as a microbial agent because it promotes the growth of crops (see FIGS. 6 to 8).
또한, 본 발명은 상기 균주, 이의 배양액 또는 상기 미생물 제제를 토양, 식물 또는 식물의 종자에 처리하는 단계를 포함하는 식물생육 촉진방법을 제공한다.In addition, the present invention provides a method for promoting plant growth, comprising the step of treating the strain, its culture or the microbial agent to soil, plants or seeds of plants.
본 발명의 ST45 및 ST502 균주는 고염 스트레스에 대해 내성을 가지며, 작물의 생육에 긍정적인 영향을 주기 위해 유용하게 사용될 수 있다(도 6 내지 도 8 참조).The ST45 and ST502 strains of the present invention are resistant to high salt stress, and may be usefully used to positively affect the growth of crops (see FIGS. 6 to 8).
상기 균주, 이의 배양액 또는 상기 미생물 제제를 고체 상태로 작물 주변의 토양에 뿌려주거나, 액체 상태로 관주, 즉 분무하거나, 작물의 종자에 침지 또는 분무하거나 종자에 코팅하여 이용할 수 있으나, 이에 제한되는 것은 아니다. 침지하는 방법의 경우, 상기 균주, 이의 배양액 또는 상기 미생물 제제를 식물체 주변의 토양에 붓거나 또는 종자를 배양액 및 제제에 담가둘 수 있다. 분무할 경우에는 당해 분야에 널리 공지된 기술로 식물체에 줄줄 흐르도록 살포할 수 있다.The strain, its culture solution or the microbial agent may be sprayed on the soil around the crop in a solid state, irrigation, that is sprayed in a liquid state, immersed or sprayed on the seed of the crop or coated on the seed, but is not limited thereto. no. In the case of the immersion method, the strain, its culture or the microbial agent may be poured into the soil around the plant or the seeds may be immersed in the culture and the preparation. In the case of spraying, it can be sprayed in a streamlined plant by techniques well known in the art.
상기 식물은 채소 작물일 수 있으며, 바람직하게는 토마토, 배추, 상추, 오이, 고추, 파 및 쑥갓 중에서 선택되는 어느 하나 이상일 수 있다.The plant may be a vegetable crop, preferably may be any one or more selected from tomatoes, cabbages, lettuce, cucumbers, peppers, green onions and garland chrysanthemum.
아울러, 본 발명은 상기 균주, 이의 배양액 또는 상기 미생물 제제를 토양, 식물 또는 식물의 종자에 처리하는 단계를 포함하는 식물의 스트레스에 대한 저항성을 증진하는 방법을 제공한다.In addition, the present invention provides a method of enhancing resistance to stress of a plant, comprising the step of treating the strain, its culture or the microbial agent to soil, a plant or a seed of a plant.
스트레스에는 다른 생물체에 의해 일어나는 생물학적(biotic) 스트레스와 물리학적 또는 화학적 환경의 변화에 의해 일어나는 非생물학적(abiotic) 스트레스가 있으며, 구체적으로 고염, 고광, 고온 또는 건조 스트레스가 있다.Stress includes biotic stress caused by other organisms and abiotic stress caused by changes in the physical or chemical environment, specifically high salt, high light, high temperature or dry stress.
본 발명의 엔테로박터 sp. ST45 균주(KCTC 11528BP) 및 ST502 균주(KCTC 11532BP)는 식물생장촉진 효과를 가지므로, 농작물에 사용되는 합성비료를 대신하여 친환경적이면서도 경제적인 미생물 비료로 사용될 수 있다.Enterobacter sp of the present invention. Since the ST45 strain (KCTC 11528BP) and ST502 strain (KCTC 11532BP) has a plant growth promoting effect, it can be used as an eco-friendly and economical microbial fertilizer in place of the synthetic fertilizer used for crops.
이하, 본 발명을 실시예에 의해 상세히 설명한다.Hereinafter, the present invention will be described in detail by way of examples.
단, 하기 실시예는 본 발명을 예시하는 것일 뿐, 본 발명의 내용이 하기 실시예에 한정되는 것은 아니다.However, the following examples are illustrative of the present invention, and the present invention is not limited to the following examples.
<<실시예Example 1> 단일 1> single콜로니Colony 스크리닝 Screening
<1-1> 토양시료<1-1> Soil Sample
스크리닝을 위한 토양시료는 한국생명공학연구원 생물자원센터에 확보되어 있는 2003년부터 2008년 국내·외 토양 500여 점과 대전지역의 밭, 논 등의 경작지 토양과 산림토양 등 250여 점 총 750여 점을 분양받아 스크리닝을 하였다.A total of 750 soil samples were screened at the Korea Institute of Bioscience and Biotechnology Center from 2003 to 2008, with about 500 domestic and foreign soils and 250 soils including arable land and rice fields in Daejeon. Points were distributed and screened.
<1-2> 스크리닝<1-2> screening
스크리닝에 사용한 배지의 구성성분은 표 1에 기재하였다. 우선, 1 g의 토양시료를 PAF 배지에 넣어 30℃, 140 rpm에서 24시간 동안 배양하였고, 배양이 끝난 1차 배양액에서 1 ㎖을 취하여 새로운 PAF 배지에 접종하여 30℃, 140 rpm에서 24시간 동안 배양하였다. 배양한 2차 배양액에서 1 ㎖을 취하여 DF 최소배지에 접종하여 30℃, 140 rpm에서 24시간 동안 배양하였다. 3차 DF 최소배양액에서 1 ㎖을 취해 4차 DF 최소배지에 접종하였고 30℃, 140 rpm에서 24시간 배양한 후 100 ㎕을 취하여 DF 최소배지에 1.5% 박토 아가를 넣어 만든 배지에 도말하여, 30℃, 140 rpm에서 48시간 배양하였다. 이때 4차용 DF 최소배지는 N-source인 (NH4)2SO4대신에 3 mM의 ACC(1-aminocyclopropane-1-carboxylate synthase)를 넣어 만든 DF 최소배지를 사용하였다.The components of the medium used for the screening are listed in Table 1. First, 1 g of soil sample was added to PAF medium and incubated at 30 ° C. and 140 rpm for 24 hours, 1 ml of the culture was completed and 1 ml of the culture was inoculated into fresh PAF medium to be incubated at 30 ° C. and 140 rpm for 24 hours. Incubated. 1 ml of the cultured secondary culture was inoculated into DF minimal medium and incubated at 30 ° C. and 140 rpm for 24 hours. 1 ml of the 3rd DF minimum culture solution was inoculated into the 4th DF minimum medium, incubated at 30 ° C and 140 rpm for 24 hours, and then 100 μl of the plate was placed in a medium made by adding 1.5% bacterium agar to the DF minimum medium. C was incubated at 140 rpm for 48 hours. At this time, the DF minimum medium for the fourth DF medium was prepared by adding 3 mM ACC (1-aminocyclopropane-1-carboxylate synthase) instead of N-source (NH4 )2 SO4 .
그 결과, 국내·외 토양 750여 점을 스크리닝하여 총 1200여 균주를 분리하였다.As a result, a total of 1200 strains were isolated by screening about 750 points of domestic and foreign soil.
(minimal medium)DF Salts
(minimal medium)
((TrypticTrypticSoySoyBrothBroth))
<<실시예Example 2> 활성 균주 스크리닝 - 2> Active Strain Screening-ACCACC 탈아미노효소 활성 측정 Deaminase Activity Measurement
토양에서 분리한 단일콜로니로 분리한 균주를 대상으로 ACC 탈아미노효소 활성을 측정하고자, 분리 균주를 TSB 배지에 접종하여 Penrose & Glick(Penrose DM & Glick BR,Can JMicrobiol 47:368-372, 2001)의 실험방법을 사용하였다. 에틸렌의 전구체인 ACC는 ACC 탈아미노효소에 의해서 α-케토뷰틸레이트(α-ketobutyrate)와 암모니아로 분해되므로, α-케토뷰틸레이트의 양을 흡광도로 측정함으로써, 분리 균주의 ACC 탈아미노효소 활성을 측정할 수 있다.In order to measure ACC deaminoase activity in a single colony isolated from soil, the isolate was inoculated in TSB medium and penrose & Glick (Penrose DM & Glick BR,CanJMicrobiol 47: 368-372, 2001). ) Was used. Since ACC, a precursor of ethylene, is decomposed into α-ketobutyrate and ammonia by ACC deaminoase, the ACC deaminoase activity of the isolated strain is determined by measuring the absorbance of α-ketobutyrate. It can be measured.
토양에서 분리한 단일콜로니로 분리한 균주를 5 ㎖의 영양배지(Nutrient broth)와 5 ㎖의 R2A 배지 또는 TSB 배지를 이용하여 30℃, 140 rpm에서 24시간 배양하였다. 24시간 후에 3000× g에서 15분간 원심분리하여 펠렛을 1.5 ㎖ 튜브로 옮기고, pH7.6인 0.1M Tris-HCl 완충용액 1 ㎖을 함께 넣어 14,000 rpm에서 5분간 원심분리하여 상층액은 버리고, pH8.5인 0.1M Tris-HCl 완충용액 600 ㎕를 넣고 파이펫팅하여 현탁시킨 후 톨루엔 300 ㎕을 넣어 30초간 강력하게 볼텍싱 하였다. 이렇게 만들어진 200 ㎕의 톨루엔화된(Toluenized) 세포를 새로운 1.5 ㎖ 튜브에 옮겨 담고 20 ㎕의 0.5M ACC를 첨가하여 볼텍싱한 후 상온에서 15분간 배양하였다. 이후 500 ㎕의 0.56M HCl을 첨가하여 볼텍싱하였고 14000 rpm에서 5분간 원심분리하였다. 상층액 500 ㎕을 새로운 튜브에 옮겨 담고 0.56M HCl 버퍼를 400 ㎕를 넣고 볼텍싱 하였다. DNPH(2,4-Dinitrophenylhydrazine) 시약 150 ㎕를 넣은 후 볼텍싱 하여 상온에서 30분간 배양한 후 1 ㎖의 2M NaOH를 넣어 UV 스펙트로미터기로 540 ㎚에서 α-케토뷰틸레이트의 양을 측정하였다.Strains isolated from single colonies isolated from soil were incubated at 30 ° C. and 140 rpm for 24 hours using 5 ml of Nutrient broth and 5 ml of R2A medium or TSB medium. After 24 hours, the pellet was transferred to a 1.5 ml tube by centrifugation at 3000 × g for 15 minutes, 1 ml of 0.1 M Tris-HCl buffer solution containing pH 7.6 was added together, and the supernatant was discarded by centrifugation at 14,000 rpm for 5 minutes. 600 μl of 0.1 M Tris-HCl buffer solution was added, suspended in pipetting, and 300 μl of toluene was added to vortex for 30 seconds. The 200 μl of toluenized cells thus prepared were transferred to a new 1.5 mL tube, vortexed with 20 μl of 0.5M ACC, and incubated at room temperature for 15 minutes. Then 500 μl of 0.56M HCl was added and vortexed and centrifuged at 14000 rpm for 5 minutes. 500 μl of supernatant was transferred to a new tube and vortexed with 400 μl of 0.56 M HCl buffer. 150 μl of DNPH (2,4-Dinitrophenylhydrazine) reagent was added thereto, followed by vortexing, incubation at room temperature for 30 minutes, and then 1 mL of 2M NaOH was added thereto to measure the amount of α-ketobutylate at 540 nm with a UV spectrometer.
분리 균주의 ACC 탈아미노효소 활성 측정에 필요한 단백질 정량은 ACC 탈아미노효소 활성 측정 중에서 톨루엔과 섞인 세포액 100 ㎕를 따로 분리하여 Coomassie Protein Assay Reagent Kit(Pierece USA)를 사용하여 595 ㎚에서 흡광도를 측정하였다. BSA(bovine serum albumin: Sigma, USA)을 표준 단백질로 사용하였다.Protein quantification required for the determination of ACC deaminoase activity of the isolated strain was measured by absorbance at 595 nm using a Coomassie Protein Assay Reagent Kit (Pierece USA). . BSA (bovine serum albumin: Sigma, USA) was used as a standard protein.
그 결과, ACC 탈아미노화 효소 활성을 나타내는 균주의 분포가 도 1에서 나타난 바와 같았다.As a result, the distribution of strains showing ACC deamination enzyme activity was as shown in FIG.
<<실시예Example 3> 16S rDNA 염기서열 분석을 통한 스크리닝 3> Screening by 16S rDNA Sequencing
ACC 탈아미노화 효소 활성값이 61 내지 80 구간이고, 재현성이 높은 것에 중점을 두어 균주를 선별한 후, 16S rDNA 염기서열을 분석함으로써 균을 동정하였다.The strains were selected by focusing on ACC deaminolase activity values of 61 to 80 sections and high reproducibility, and then identifying the bacteria by analyzing 16S rDNA sequences.
우선, 상기 선별된 균주로부터 DNA를 추출한 후, 상기 DNA를 주형으로 서열번호 1로 기재되는 정방향 프라이머(5'-AGAGTTTGATCCTGGCTCAG-3') 및 서열번호 2로 기재되는 역방향 프라이머(5'-GGTTACTTGTTACGACTT-3') 10 p㏖을 이용하여 PCR Thermal cycler TP600(Takara Co. Japan) 기기에서 하기 조건으로 PCR을 수행하였다: PCR 조건은 변성은 94℃에서 1분; 어닐링은 50℃에서 45 분; 신장은 72℃에서 3분; 30 회 반복. PCR 산물은 QIAquick PCR purification Kit(Qiagen)를 이용하여 정제한 후, Applied Bosystems model 310 automatic DNA sequencer로 염기서열을 분석하였다.First, after extracting the DNA from the selected strains, the forward primer (5'-AGAGTTTGATCCTGGCTCAG-3 ') described in SEQ ID NO: 1 as the template and the reverse primer (5'-GGTTACTTGTTACGACTT-3) described in SEQ ID NO: 2 ') PCR was carried out on the PCR Thermal cycler TP600 (Takara Co. Japan) instrument using 10 mmol, with the following conditions: PCR conditions were 1 min at 94 ° C; Annealing at 45 ° C. for 45 minutes; Elongation 3 min at 72 ° C .;
수득한 16S rDNA의 염기서열을 NCBI의 BLAST 프로그램을 이용하여 분석하여 표 2에 기재하였다. 그 중, ACC 탈아미노화 효소 활성이 높고 유사도가 낮은, 동일한 엔테로박터속의 균주 2주(Serial No. BN084045: 서열번호 3, BN084502: 서열번호 4)를 최종적으로 선발하였고, ST45 및 ST502로 명명하였다.The base sequence of the obtained 16S rDNA was analyzed by using the BLAST program of NCBI and shown in Table 2. Among them, two strains of the same Enterobacter strain (Serial No. BN084045: SEQ ID NO: 3, BN084502: SEQ ID NO: 4) having high ACC deamination enzyme activity and low similarity were finally selected and named ST45 and ST502. .
activityACC deaminase
activity
<<실시예Example 4> 4>활성균주Active strainST45ST45 동정 Sympathy
<4-1> 균주배양<4-1> Strain Culture
기본배지로서 TSA(Tryptic Soy Agar) 배지에서 ST45를 배양하였으며, pH7.0의 배지에 접종하여 30℃에서 24시간 배양하였다. 균주의 보존은 최종 농도 20%로 글리세롤을 포함하도록 하여 냉동 보관하였다.ST45 was incubated in TSA (Tryptic Soy Agar) medium as a basic medium, and inoculated in medium of pH 7.0 and incubated at 30 ° C. for 24 hours. Preservation of the strain was stored frozen to include glycerol at a final concentration of 20%.
<4-2> 계통분류학적 분석<4-2> Phylogenetic Analysis
실시예 3에서 확인한 바와 같이, 엔테로박터속으로 분류된, 선발한 ST45 균주 및 ST502 균주의 16S rDNA 염기서열을 엔테로박터속 내의 종(enterobacter species) 및 그 외의 관련된 분류군과 비교하기 위해, CLUSTAL W 프로그램으로 분석하였다. 16S rDNA의 유사도는 Similarity Matrix version 1.1(Ribosomal Database Project Ⅱ; //rdp.cme.msu.dcu/html/analysis.html)을 이용하여 계산하였으며, 염기서열 중 갭(gap) 부분은 분석에서 제외되었다. Evolutionary distance matrix는 PHYLIP(Phylogeny inference package, Felsenstein, 1993)의 dnadist 프로그램을 이용하였다. 분자계통도는 거리행렬법 중의 하나인 Neighbour-joining 방법을 사용하여 구성하였다. Bootstrap 분석은 PHYLIP 패키지의 Kimura 2-parameter 모델의 알고리즘을 이용하여 수행하였다(Kimura M, JMolEvol 16,:111-120, 1980).As confirmed in Example 3, the CLUSTAL W program was used to compare 16S rDNA sequences of selected ST45 strains and ST502 strains, classified into Enterobacter, with enterrobacter species and other related taxa. Analyze by. The similarity of 16S rDNA was calculated using Similarity Matrix version 1.1 (Ribosomal Database Project II; //rdp.cme.msu.dcu/html/analysis.html), and the gap portion of the base sequence was excluded from the analysis. . For the evolutionary distance matrix, the dnadist program of PHYLIP (Phylogeny inference package, Felsenstein, 1993) was used. Molecular system was constructed using the neighbor-joining method, one of the distance matrices. Bootstrap analysis was performed using the algorithm of Kimura 2-parameter model of PHYLIP package (Kimura M,
그 결과, 도 2와 같은 계통수를 수득하였는데, ST45 및 ST502는 계통적으로 엔테로박터속 내에 위치하고 있었고, 부트스트랩 수치(bootstrap value)가 이를 뒷받침하였다. 또한, 본원발명의 ST45의 16S rDNA는 엔테로박터 캔세로지너스(Enterobactercancerogenus: 97.1%), 엔테로박터 아스부리애(Enterobacterasburiae: 96.7%) 및 엔테로박터 루드위지(Enterobacterludwigii: 96.7%) 순으로 높은 유사도를 나타내었다. 또한, ST502의 16S rDNA는 엔테로박터 호매치(Enterobacterhormaechei: 98.4%), 엔테로박터 파이리너스(Enterobacterpyrinus: 95.9%), 엔테로박더 거고비에(Enterobactergergoviae: 95.8%) 순으로 높은 유사도를 나타내었다.As a result, a phylogenetic tree as shown in FIG. 2 was obtained, in which ST45 and ST502 were systematically located in Enterobacter, supported by a bootstrap value. In addition, the 16S rDNA of the ST45 of the present invention is Enterobacter canserogenus (Enterobactercancerogenus : 97.1%),Enterobacterasburiae: 96.7%) and Enterobacter Ruud tea(Enterobacterludwigii : 96.7%) showed the highest similarity. The ST502's 16S rDNA also containsEnterobacterhormaechei : 98.4%),Enterobacterpyrinus : 95.9%), Enterobacter giantgovier (Enterobactergergoviae : 95.8%).
<4-3> 형태적 특성 조사<4-3> Morphological Characteristics
실시예 4-1의 방법으로 배양한 균주의 형태학적 특성을 조사하기 위하여 "Mannual of Methods for General Bacteriology"(John GHetal.,Bergey's Mannual of Determinative Bacteriology, 9th(ed.), Williams and Wilkins, Baltiomore, 1994)의 방법을 따랐으며, 크기, 운동성, 그람 염색법, 표면색 등을 광학현미경을 이용하여 관찰하였고, 편모(flagella)를 확인하기 위해 투과전자현미경(Transmission Electron Microscopy: TEM)을 이용하여 관찰하였다.In order to investigate the morphological characteristics of the strains cultured by the method of Example 4-1, "Mannual of Methods for General Bacteriology" (John GHetal. , Bergey's Mannual of Determinative Bacteriology, 9th (ed.), Williams and Wilkins, Baltiomore, 1994) was used, and the size, motility, gram staining, and surface color were observed using an optical microscope and flagella was identified. In order to observe it using a Transmission Electron Microscopy (TEM).
분석 결과를 표 3에 기재하였으며, ST45 및 ST502는 그람 음성으로 확인되었다. ST45는 TSA 배지에서 짙은 크림색을 띄었다(도 3). 24시간 배양 후 광학현미경으로 관찰 시 ST45는 둥글면서 규칙적인 형태를 보였으며, 표면에는 한 가닥의 편모를 형성함으로써 운동성을 갖는 것으로 나타났다(도 4a). ST502는 TSA배지에서 유백색의 밝은 크림색을 띄었다. 24시간 배양 후 광학현미경으로 관찰시 ST502는 둥글면서 약간 타원형의 형태를 보였으며, 표면에는 편모를 형성하지 않았다 (도 4b).The analytical results are shown in Table 3, and ST45 and ST502 were confirmed gram negative. ST45 was dark cream in TSA medium (FIG. 3). When observed under an optical microscope after 24 hours of incubation, the ST45 showed a round and regular shape, and was found to have mobility by forming a single flagella on the surface (FIG. 4A). The ST502 had a milky bright creamy color on the TSA medium. When observed by optical microscope after 24 hours of incubation, ST502 was round and slightly oval in shape, and did not form flagella on the surface (FIG. 4B).
또한, 표 3에 나타난 바와 같이 ST45 및 ST502는 계통수에서 가깝게 위치하는 균주들과 형태적 특징을 비교해 보았을 때 형태학적으로 차이가 있음을 알 수 있었다. 즉, 엔테로박터 캔세로지너스는 막대모양을 띄며 운동성을 갖지만, 엔테로박터 아스부리애는 운동성을 갖지 않았다.In addition, as shown in Table 3, ST45 and ST502 were found to be morphologically different when compared with the morphological characteristics of the strains located close to the phylogenetic tree. In other words, Enterobacter cancerogenus is rod-shaped and has mobility, but Enterobacter asbria has no mobility.
oxytocaoxytoca
asburiaeasburiae
×1.2-3.00.7-1.0
× 1.2-3.0
×0.8-3.00.4-1.0
× 0.8-3.0
×1.2-3.00.6-1.0
× 1.2-3.0
×0.6-6.00.3-1.0
× 0.6-6.0
×1.2-3.00.6-1.0
× 1.2-3.0
* nd: not determined* nd: not determined
<4-4> 생리적 특성 조사<4-4> Physiological Characteristics
API Kit과 BIOLOG Kit를 이용하여 탄소원으로서 당 이용성 및 전분 분해 시험 등 각종 효소에 관한 실험을 실행하였다. 또한 균주의 생육조건을 알아보기 위하여 pH가 5.0-11.0까지 조정된 TSA 배지에 접종하여, 30℃에서 4일간 관찰하였다. pH5.0-8.0은 Na2HPO4-H2PO4 완충용액, pH8.0-10.0은 Na2CO3-NaHCO3 완충용액, PH 11.0은 Na2HPo4-NaOH 완충용액을 이용하여 조정하였다. 생육온도 및 생육 최적온도는 10-50℃의 범위에서의 균주의 성장을 관찰하였다. NaCl의 염농도에서의 생육도를 측정하기 위해 0% 내지 10%까지 TSA 배지에 NaCl(v/v)을 첨가하여 최적환경 pH 및 온도에서 배양하면서 그 생육 정도를 관찰하였다.Using the API Kit and the BIOLOG Kit, experiments were conducted on various enzymes such as sugar availability and starch decomposition test as carbon sources. In addition, in order to determine the growth conditions of the strain was inoculated in TSA medium adjusted to pH 5.0-11.0, and observed for 4 days at 30 ℃. pH 5.0-8.0 was adjusted with Na2 HPO4 -H2 PO4 buffer, pH 8.0-10.0 with Na2 CO3 -NaHCO3 buffer, and PH 11.0 with Na2 HPo4 -NaOH buffer. . Growth temperature and growth optimum temperature were observed for the growth of the strain in the range of 10-50 ℃. In order to measure the growth of NaCl in salt concentration, NaCl (v / v) was added to TSA medium from 0% to 10%, and the growth thereof was observed while incubating at an optimal environment pH and temperature.
그 결과, 표 3에 나타난 바와 같이 ST45는 에스큘린(esculin)은 가수분해하였으나, 우레아는 분해하지 못했다. 탄소원으로는 D-라피노오스(raffinose) 및 D-멜리보우즈(melibiose)를 이용하였으며, 아도니톨(adonitol), 덜시톨(dulcitol), D-솔비톨, 슈크로스, L-과당은 이용하지 않았다. 또한, 트롤린도마이신(troleandomycin; 100 ㎍/㎖), 리파마이신 5v(rifamycin 5v; 100 ㎍/㎖), 미노싸이클린(minocycline; 100 ㎍/㎖), 밴코마이신(vancomycin; 100 ㎍/㎖)에 대하여 감수성을 보였다(데이타 없음). 또한, TSA 배지에서 8% 이상의 염농도에서 생육이 저하되는 것으로 나타났다. 또한 4℃에서는 성장하지 못하였고 28℃-35℃에서 최적 성장을 보였으며 45℃ 이상에서는 성장하지 못하거나 더디었다. 최적 pH는 5-8이었다.As a result, as shown in Table 3, ST45 hydrolyzed esculin, but not urea. D-raffinose and D-melibiose were used as carbon sources, and adonitol, dulcitol, D-sorbitol, sucrose, and L-fructose were not used. Did. In addition, troleandomycin (100 µg / ml), rifamycin 5v (rifamycin 5v; 100 µg / ml), minocycline (100 µg / ml), vancomycin (100 µg / ml) Sensitivity was shown (no data). It was also shown that growth was lowered at salt concentrations of 8% or higher in TSA medium. Also, it did not grow at 4 ℃, showed optimal growth at 28 ℃ -35 ℃, and did not grow or slowed at above 45 ℃. Optimal pH was 5-8.
또한, ST502는 에스큘린(esculin)은 가수분해하지 못하였고, 탄소원으로는 아도니톨, D-솔비톨, D-자일로오스, 만니톨, 슈크로스, D-라피노오스 및 D-멜리보우즈를 이용하였으며, L-과당은 이용하지 않았다. 또한, TSA 배지에서 8% 이상의 염농도에서 생육이 저하되는 걸로 나타났다. 또한 4℃에서는 성장하지 못하였고 28℃-35℃에서 최적 성장을 보였으며 45℃ 이상에서는 성장하지 못하거나 더디었다. 최적 pH는 6-8이었다.In addition, ST502 did not hydrolyze esculin, and as a carbon source, adonitol, D-sorbitol, D-xylose, mannitol, sucrose, D-rapinose and D-meliboose No L-fructose was used. It was also shown that growth was lowered at salt concentrations of 8% or higher in TSA medium. Also, it did not grow at 4 ℃, showed optimal growth at 28 ℃ -35 ℃, and did not grow or slowed at above 45 ℃. The optimal pH was 6-8.
<4-5> 화학적 특성 조사 - 세포벽 지방산 조성분석<4-5> Chemical Characterization-Cell Fatty Acid Composition Analysis
MIDI(Microbial ID)를 이용한 균체 지방산 분석을 위하여 균주는 TSB 배지에서 24시간 동안 최적 조건에서 배양(30℃, 140 rpm)한 후 원심 분리하여 균체만 회수하여 동결건조 하였다. 회수한 균체 약 50 ㎎을 Teflon-lined screw cap 튜브(13 × 100 ㎜, pyrex)에 옮긴 후, 표 4의 시약 1을 1 ㎖ 넣고 100℃에서 30분간 가열하고 실온에서 식혔다. 이어서 시약 2를 2 ㎖ 첨가하여 80℃에서 10분간 가열한 후 급랭하였고, 시약 3을 1.25 ㎖ 넣고 10분간 섞어주었다. 실온에 정치한 다음 반응액이 2개의 층으로 분리되면 하층액을 제거하고, 시약 4를 3 ㎖ 첨가하여 5분간 섞어준 다음, 반응액 중에서 상등액의 2/3를 새로운 바이알로 옮겨 분석 시료로 하였다. FAMEs(fatty acid methyl esters)의 분석에는 가스크로마토그래피(Hewlett Packard series Ⅱ model 6890A, Delaware, USA)를 이용하였으며, methyl phenyl silicone fused silica capillary 컬럼(25 m × 0.22 ㎜ × 0.33 m, Hewlett Packard, USA)을 사용하였다.For cell fatty acid analysis using Microbial ID (MIDI), the strains were cultured in TSB medium for 24 hours at optimal conditions (30 ° C, 140 rpm) and then centrifuged to recover only the cells and lyophilized. About 50 mg of the recovered cells was transferred to a Teflon-lined screw cap tube (13 × 100 mm, pyrex), 1 ml of Reagent 1 in Table 4 was added thereto, heated at 100 ° C. for 30 minutes, and cooled at room temperature. Subsequently, 2 ml of
그 결과, 표 5에 나타난 바와 같이 ST45의 주요 지방산은 C12:0(7.99%), C14:0(6.46%), C15:0(1.39%), C16:0(18.98%), C17:0cyclo(14.24%), C17:0(1.74%) 및 C18:1ω7c(20.59%) 이었다. 엔테로박터속 세포벽 지방산 조성과 일치하였다.As a result, as shown in Table 5, the major fatty acids of ST45 were C12: 0 (7.99%), C14: 0 (6.46%), C15: 0 (1.39%), C16: 0 (18.98%), C17: 0 cyclo (14.24%), C17: 0 (1.74%) and C18: 1ω 7c (20.59%). It was consistent with the Enterobacter cell wall fatty acid composition.
*Summed feature 2: iso-C16:1 I 및/또는 C14:0 3OH를 하나 이상 포함* Summed feature 2: Contains at least one iso-C16: 1 I and / or C14: 0 3OH
*Summed feature 3: C16:1w7c 및/또는 iso-C15:0 2OH를 하나 이상 포함.* Summed feature 3: Include at least one C16: 1 w7c and / or iso-C15: 0 2OH.
또한, 표 6에 나타난 바와 같이 ST502의 주요 지방산은 C12:0(4.17%), C14:0(10.44%), C15:0(5.01%), C16:0(20.26%), C17:0cyclo(14.40%), C17:0(2.41%) 및 C18:1ω7c(13.66%) 로 ST45의 주요 지방산 성분과 유사하여 동일한 엔테로박터속으로서의 특성을 나타냈다.In addition, as shown in Table 6, the major fatty acids of ST502 are C12: 0 (4.17%), C14: 0 (10.44%), C15: 0 (5.01%), C16: 0 (20.26%), C17: 0 cyclo (14.40%), C17: 0 (2.41%), and C18: 1ω 7c (13.66%), similar to the main fatty acid component of ST45, exhibited the same characteristics as the enterobacter genus.
*Summed feature 2: iso-C16:1 I 및/또는 C14:0 3OH를 하나 이상 포함* Summed feature 2: Contains at least one iso-C16: 1 I and / or C14: 0 3OH
*Summed feature 3: C16:1w7c 및/또는 iso-C15:0 2OH를 포함.* Summed feature 3: Includes C16: 1 w7c and / or iso-C15: 0 2OH.
<4-6> 분자생물학적 특성 조사 - G+C 몰% 함량 측정<4-6> Molecular Biology Characterization-G + C mol% content measurement
근연 계통일수록 염색체 DNA의 염기조성이 비슷하다는 가정하에서, 4 염기(adenine, guanine, thymine, cytosine) 중에서 구아닌과 시토신이 차지하는 비율(GC 함량)을 몰%로 조사함으로써, 신종의 분자 유전학적 분류지표로 삼을 수 있다. 이에, ST45의 분자생물학적 특성을 조사하기 위해, 염색체 DNA의 G+C 함량 몰%를 분석하였다.Under the assumption that the baseline of chromosomal DNA is more similar in recent years, a new molecular genetic classification index is obtained by investigating the ratio (GC content) of guanine and cytosine (GC content) among 4 bases (adenine, guanine, thymine and cytosine). Can be made In order to investigate the molecular biological properties of ST45, the mole% G + C content of chromosomal DNA was analyzed.
우선, ST45의 DNA를 추출한 후 멸균증류수 10 ㎕(1 ㎍/㎕)에 용해시켜 100℃에서 5분간 열처리하여 DNA를 변성시킨 후 얼음 속으로 옮겼다. 열 변성된 DNA에 뉴클라아제 P1을 처리하여 뉴클레오티드로 만든 뒤 역상컬럼(GROM-SIL 120 DOS5-ST, GRO)을 부착한 HPLC(Shimadzu Co. Japan)를 표 7의 조건으로 작동하여 260 ㎚ 파장에서 흡광도를 측정함으로써 G+C 함량을 결정하였다.First, the DNA of ST45 was extracted, dissolved in 10 μl of sterile distilled water (1 μg / μl), and heat-treated at 100 ° C. for 5 minutes to denature the DNA, and then transferred to ice. Nuclease P1 was treated with heat-denatured DNA to make nucleotides, and then HPLC (Shimadzu Co. Japan) with a reversed phase column (GROM-SIL 120 DOS5-ST, GRO) was operated under the conditions shown in Table 7 to operate at 260 nm wavelength. The G + C content was determined by measuring the absorbance at.
그 결과, ST45의 DNA G+C 함량은 55.4몰%로 다른 엔테로박터속의 종(52-60몰%)에서 보고된 함량 범위 내에 속하였다.As a result, the DNA G + C content of ST45 was 55.4 mol%, which was within the reported content range of other Enterobacter species (52-60 mol%).
<<실시예Example 5> 5>ACCACC탈아미노화Deaminoation 효소 활성 및 Enzyme activity andIAAIAA((indoleindoleaceticaceticacidacid) 측정) Measure
ST45, ST502 및 대조균주로 슈도모나스 플로레센스(Pseudomonas fluorescens)의 ACC 탈아미노화 효소 활성 및 IAA(indole acetic acid) 농도를 측정하였다.ST45, ST502, and control strains were used to determine the ACC deamination activity and indium acetic acid (IAA) concentrations ofPseudomonas fluorescens .
ACC 탈아미노화 효소 활성은 실시예 2의 방법으로 측정하였다.ACC deamination enzyme activity was measured by the method of Example 2.
IAA 농도 측정은 영양배지에서 24시간 배양한 배양액에서 100 ㎕를 취하여 500 ㎍/㎖ L-트립토판(Sigma-Aldrich Co., U.S.A.)이 함유된 50 ㎖의 LB 배지에 접종하여 28℃에서 7일간 배양하였다. 배양액을 10,000 rpm에서 15분간 원심분리하여 세포를 제거한 후, 상층액 2 ㎖과 100 ㎕의 10 mM 오르토인산(orthophosphoric acid)을 4 ㎖의 Salkowski`s 시약에 첨가하여 혼합한 후, 상온에서 25분간 배양하고 분홍빛이 되면 흡광도 530 ㎚에서 측정하였다. IAA(indole-3-acetic acid; Sigma-Aldrich Co., U.S.A.)를 배양 배지에 농도별로 녹여서 표준 곡선을 작성하였다.IAA concentration was measured by incubation in 50 ml LB medium containing 500 μg / ml L-tryptophan (Sigma-Aldrich Co., USA) in culture medium incubated for 24 hours in nutrient medium and incubated at 28 ° C for 7 days. It was. Cells were removed by centrifugation of the culture solution at 10,000 rpm for 15 minutes, 2 ml of supernatant and 100 µl of 10 mM orthophosphoric acid were added to 4 ml of Salkowski`s reagent, mixed and mixed for 25 minutes at room temperature. When cultured and became pink, the absorbance was measured at 530 nm. Standard curves were prepared by dissolving IAA (indole-3-acetic acid; Sigma-Aldrich Co., U.S.A.) at different concentrations in the culture medium.
그 결과, 도 5에 나타난 바와 같이 ST45 및 ST502의 ACC 탈아미노화 효소 활성값은 대조균주인 슈도모나스 플로레센스와 비교하여 3~4배 이상 높게 나왔다. 또한, ST45 및 ST502 균주와 대조균주인 슈도모나스 플로레센스가 옥신을 생성함을 확인할 수 있었고, ST45 및 ST502에서 대조균주보다 옥신의 생성수치가 낮은 것을 확인하였다. 이것은 ST45가 작물과 협력하여 작물 내의 에틸렌 농도를 조절함으로써 작물의 생장에 긍정적인 영향을 줄 수 있음을 암시하는 것이다.As a result, as shown in FIG. 5, the ACC deamination enzyme activity values of ST45 and ST502 were 3-4 times higher than those of the control strain Pseudomonas florescens. In addition, it was confirmed that Pseudomonas floressen, which is a control strain with the ST45 and ST502 strains, produced auxin. This suggests that ST45 can have a positive effect on crop growth by co-operating with crops to adjust the ethylene concentration in the crops.
<<실시예Example 6> 식물의 생장촉진 효과 - 6> Plant Growth Effect-PotPot 실험 Experiment
ST45 및 ST502가 고염 상태에서 토마토의 생장에 미치는 영향을 알아보기 위하여 토마토 포트에 처리한 후, 재배하였다. 줄기부분이 약 5 ㎝ 이상인 토마토 묘목['서광', 세미니스코리아㈜]을 대상으로, 121℃에서 30분간 멸균한 상토['원예용 상토 하이', 부농㈜]를 지름 9 ㎝,깊이 8 ㎝인 포트에 각각 약 130 g씩 담았다. ST45를 TSB 배지에서 30℃, 140 rpm에서 24시간 배양한 후 흡광도 600 ㎚에서 1.0으로 농도를 조정한 후, 포트에 30 ㎖를 처리하였다. 균주액을 처리 한 후 각각의 포트에 NaCl을 0 mM 및 210 mM/L의 농도로 처리하여 인위적으로 고염 스트레스를 가하였다. 일정한 염 농도(210 mM = 1.2%)를 조성하도록, 트레이를 이용하여 물을 주입하였다. 4주간 배양 및 관찰한 후, 토마토 묘목의 줄기 및 뿌리 크기 측정 및 생체질량을 측정하여 ANOVA를 이용하여 통계 분석하였다.In order to determine the effect of ST45 and ST502 on the growth of tomatoes in the high salt state, it was cultivated after processing in tomato pot. For tomato seedlings [Seowang], Seminis Korea Co., Ltd. whose stems are about 5 cm or more, the soil ['Horticulture Sae High', Bunon Co., Ltd.] sterilized at 121 ° C. for 30 minutes is 9 cm in diameter and 8 cm in depth. Each pot was about 130 g. After incubating the ST45 in TSB medium at 30 ° C. for 24 hours at 140 rpm, the concentration was adjusted to 1.0 at 600 nm of absorbance, and then 30 ml of the pot was treated. After treating the strain solution, each pot was treated with NaCl at concentrations of 0 mM and 210 mM / L to artificially apply high salt stress. Water was injected using a tray to create a constant salt concentration (210 mM = 1.2%). After incubation and observation for 4 weeks, stem and root size measurements and biomass of tomato seedlings were measured and statistically analyzed using ANOVA.
그 결과, 도 6 내지 도 8에 나타난 바와 같이 ST45 및 ST502를 처리하지 않은 대조군의 경우, 줄기는 7.01±2.9(cm), 뿌리는 8.87±2.5(cm)로 측정되었고, ST45 처리군의 경우, 줄기는 11.55±4.2(cm), 뿌리는 13.9±2.7(cm)로 측정되었다. 또한, 대조군에 비해 ST45 및 ST502 처리군의 토마토가 수치상 생장이 더 나은 것을 확인할 수 있었고, 이로부터 ST45 및 ST502가 식물의 생장촉진에 긍정적인 영향을 주는 것을 확인하였다.As a result, as shown in Figures 6 to 8 for the control group not treated with ST45 and ST502, the stem was measured to 7.01 ± 2.9 (cm), roots 8.87 ± 2.5 (cm), in the case of the ST45 treatment group, The stems were 11.55 ± 4.2 cm and the roots were 13.9 ± 2.7 cm. In addition, it was confirmed that the tomato growth of the ST45 and ST502 treated group better than the control group, from which it was confirmed that the ST45 and ST502 positively affect the growth of the plant.
도 1은 스크리닝된 균주들의 측정된 ACC 탈아미노화 활성의 분포를 나타낸 도이다.1 is a diagram showing the distribution of measured ACC deaminoation activity of screened strains.
도 2는 본원발명의 ST45 및 ST502와 근연한 균주들의 계통수를 나타낸 도이다.Figure 2 is a diagram showing the phylogenetic tree of strains in close proximity to the ST45 and ST502 of the present invention.
도 3은 본원발명의 ST45의 콜로니 형성 모습을 나타낸 도이다.3 is a view showing a colony formation state of the ST45 of the present invention.
도 4는 본원발명의 ST45 및 ST502의 형태를 나타낸 도이다:4 is a view showing the form of the ST45 and ST502 of the present invention:
a: ST45; 및,a: ST45; And,
b: ST502.b: ST502.
도 5는 본원발명의 ST45 및 ST502의 ACC 탈아미노화 활성 및 IAA 농도 측정 결과를 나타낸 도이다.5 is a diagram showing the results of ACC deaminoation activity and IAA concentration measurement of ST45 and ST502 of the present invention.
도 6 내지 도 8은 본원발명의 ST45 및 ST502가 토마토 묘목의 생육에 미치는 영향을 나타낸 도이다:6 to 8 are diagrams showing the effect of ST45 and ST502 of the present invention on the growth of tomato seedlings:
6: 생육의 그래프 데이타;6: graph data of growth;
7: 생육의 사진 데이타; 및,7: photographic data of growth; And,
8: 뿌리 및 줄기 성장 사진.8: Root and Stem Growth Photo.
<110> Korea Research Institute of Bioscience and Biotechnology<120> Novel Enterobacter sp. strains and method for stimulating the growth of plant by using them<130> 9P-07-06<160> 4<170> KopatentIn 1.71<210> 1<211> 20<212> DNA<213> Artificial Sequence<220><223> forward primer<400> 1agagtttgat cctggctcag 20<210> 2<211> 18<212> DNA<213> Artificial Sequence<220><223> reverse primer<400> 2ggttacttgt tacgactt 18<210> 3<211> 1408<212> DNA<213> ST45 16S rDNA<400> 3ataaagnttg tgggaccatg cagtcgaacg gtagcacaga gagcttgctc tcgggtgacg 60aggggggacg ggtgagtaat gtctgggaaa ctgcctgatg gagggggata actactggaa 120acggtagcta ataccgcata acgtctcaag accaaagagg gggaccttcg ggcctcttgc 180catcacatgt gcccacatgg gattatctat taggtggggt aacggctcac ctatgcgaca 240atccctatct ggtctgagag gatgaccacc cacactggaa ctgagacacg gtccacactc 300ctacgggagg cagcagtggg gaatattgca caatggcgca cctgatgccc tgccgcgtgt 360atgaaaagcc ttcgggttgt aaagtacttt cagcggggag gaaggcgata cggttaataa 420ccgtgtcgat tgacgttacc cgcaaaaaca ccggctaact ccgtgccagc agccgcggta 480atacggaggg tgcaagcgtt aatcggaatt actgggcgta aagcgcacgc agcggtctgt 540caagtcggat gtgaaatccc cgggctcaac ctgggaactg cattcgaaac tggcaggctt 600gagtcttgta gaggggggta gaattccagg tgtagcggtg aaatgcgtaa gatctggagg 660aataccggtg gcgaagcggc cccctggaca aagactgacg ctcaggtgcg aaagcgtggg 720gagcaaacag gattaatacc ctggtagtcc acgctgtaaa cgatgtctat ttggaggttg 780tgcccttgag gcgtggcttc cggagctaac gcgttaaata accgcctggg gagtacggcc 840gcaaggttaa aactcaatga attgacgggg gcccgcacaa gcggtggagc atgtggttta 900attcgatgca acgcgaagaa ccttacctac tcttgacatc cagagaactt gcagagatgc 960ttggtgcctt cgggaactct gagacaggtg ctgcatggct gtcgtcagct cgtgttgtga 1020aatgttgggt taagtcccgc aacgagcgca acccttatcc tttgttgcca gcgattcggc 1080gggaactcaa aggagactgc cagtgataaa ctggaggaag gtggggatga cgtcaagtca 1140tcatggccct tacgagtagg gctacacacg tgctacaatg gcgcatacaa agagaagcga 1200actcgcgaga gcaagcggac ctcataaagt gcgtcgtagt ccggatcgga gtctgcaact 1260cgactccgtg aagtcggaat cgctagtaat cgtggatcag aatgccacgg tgaatacgtt 1320cccgggcctt gtacacaccg cccgtcacac catgggagtg ggttgcaaaa gaagtaggta 1380gcttaacctc gggagggcgc taccactt 1408<210> 4<211> 1432<212> DNA<213> ST502 16S rDNA<400> 4aggggggcaa gctacacatg caagtcgaac ggtaacagga agcagcttgc tgcttcgctg 60acgagtggcg gacgggtgag taatgtctgg gaaactgcct gatggagggg gataactact 120ggaaacggta gctaataccg cataacgtcg caagaccaaa gagggggacc ttcgggcctc 180ttgccatcgg atgtgcccag atgggattag ctagtaggtg gggtaacggc tcacctaggc 240gacgatccct agctggtctg agaggatgac cagccacact ggaactgaga cacggtccag 300actcctacgg gaggcagcag tggggaatat tgcacaatgg gcgcaagcct gatgcagcca 360tgccgcgtgt atgaagaagg ccttcgggtt gtaaagtact ttcagcgggg aggaaggcga 420taggttaata accttgtcga ttgacgttac ccgcagaaga agcaccggct aactccgtgc 480cagcagccgc ggtaatacgg agggtgcaag cgttaatcgg aattactggg cgtaaagcgc 540acgcaggcgg tctgtcaagt cggatgtgaa atccccgggc tcaacctggg aactgcattc 600gaaactggca ggctagagtc ttgtagaggg gggtagaatt ccaggtgtag cggtgaaatg 660cgtagagatc tggaggaata ccggtggcga aggcggcccc ctggacaaag actgacgctc 720aggtgcgaaa gcgtggggag caaacaggat tagataccct ggtagtccac gccgtaaacg 780atgtcgactt ggaggttgtg cccttgaggc gtggcttccg gagctaacgc gttaagtcga 840ccgcctgggg agtacggccg caaggttaaa actcaaatga attgacgggg gcccgcacaa 900gcggtggagc atgtggttta attcgatgca acgcgaagaa ccttacctac tcttgacatc 960cagagaactt acagagatgg attggtgcct tcgggaactc tgagacaggt gctgcatggc 1020tgtcgtcagc tcgtgttgtg aaatgttggg ttaagtcccg caacgagcgc aacccttatc 1080ctttgttgcc agcggtcggc cgggaactca aaggagactg ccagtgataa actggaggaa 1140ggtggggatg acgtcaagtc atcatggccc ttacgagtag ggctacacac gtgctacaat 1200ggcgcataca aagagaagcg acctcgcgag agcaagcgga cctcataaag tgcgtcgtag 1260tccggattgg agtctgcaac tcgactccat gaagtcggaa tcgctagtaa tcgtggatca 1320gaatgccacg gtgaatacgt tcccgggcct tgtacacacc gcccgtcaca ccatgggagt 1380gggttgcaaa agaagtaggt agcttaacct tcgggagggc gctaccattt tt 1432<110> Korea Research Institute of Bioscience and Biotechnology<120> Novel Enterobacter sp. strains and method for stimulating the growth of plant by using them<130> 9P-07-06<160> 4<170> KopatentIn 1.71<210> 1<211> 20<212> DNA<213> Artificial Sequence<220><223> forward primer<400> 1agagtttgat cctggctcag 20<210> 2<211> 18<212> DNA<213> Artificial Sequence<220><223> reverse primer<400> 2ggttacttgt tacgactt 18<210> 3<211> 1408<212> DNA<213> ST45 16S rDNA<400> 3ataaagnttg tgggaccatg cagtcgaacg gtagcacaga gagcttgctc tcgggtgacg 60aggggggacg ggtgagtaat gtctgggaaa ctgcctgatg gagggggata actactggaa 120acggtagcta ataccgcata acgtctcaag accaaagagg gggaccttcg ggcctcttgc 180catcacatgt gcccacatgg gattatctat taggtggggt aacggctcac ctatgcgaca 240atccctatct ggtctgagag gatgaccacc cacactggaa ctgagacacg gtccacactc 300ctacgggagg cagcagtggg gaatattgca caatggcgca cctgatgccc tgccgcgtgt 360atgaaaagcc ttcgggttgt aaagtacttt cagcggggag gaaggcgata cggttaataa 420ccgtgtcgat tgacgttacc cgcaaaaaca ccggctaact ccgtgccagc agccgcggta 480atacggaggg tgcaagcgtt aatcggaatt actgggcgta aagcgcacgc agcggtctgt 540caagtcggat gtgaaatccc cgggctcaac ctgggaactg cattcgaaac tggcaggctt 600gagtcttgta gaggggggta gaattccagg tgtagcggtg aaatgcgtaa gatctggagg 660aataccggtg gcgaagcggc cccctggaca aagactgacg ctcaggtgcg aaagcgtggg 720gagcaaacag gattaatacc ctggtagtcc acgctgtaaa cgatgtctat ttggaggttg 780tgcccttgag gcgtggcttc cggagctaac gcgttaaata accgcctggg gagtacggcc 840gcaaggttaa aactcaatga attgacgggg gcccgcacaa gcggtggagc atgtggttta 900attcgatgca acgcgaagaa ccttacctac tcttgacatc cagagaactt gcagagatgc 960ttggtgcctt cgggaactct gagacaggtg ctgcatggct gtcgtcagct cgtgttgtga 1020aatgttgggt taagtcccgc aacgagcgca acccttatcc tttgttgcca gcgattcggc 1080gggaactcaa aggagactgc cagtgataaa ctggaggaag gtggggatga cgtcaagtca 1140tcatggccct tacgagtagg gctacacacg tgctacaatg gcgcatacaa agagaagcga 1200actcgcgaga gcaagcggac ctcataaagt gcgtcgtagt ccggatcgga gtctgcaact 1260cgactccgtg aagtcggaat cgctagtaat cgtggatcag aatgccacgg tgaatacgtt 1320cccgggcctt gtacacaccg cccgtcacac catgggagtg ggttgcaaaa gaagtaggta 1380gcttaacctc gggagggcgc taccactt 1408<210> 4<211> 1432<212> DNA<213> ST502 16S rDNA<400> 4aggggggcaa gctacacatg caagtcgaac ggtaacagga agcagcttgc tgcttcgctg 60acgagtggcg gacgggtgag taatgtctgg gaaactgcct gatggagggg gataactact 120ggaaacggta gctaataccg cataacgtcg caagaccaaa gagggggacc ttcgggcctc 180ttgccatcgg atgtgcccag atgggattag ctagtaggtg gggtaacggc tcacctaggc 240gacgatccct agctggtctg agaggatgac cagccacact ggaactgaga cacggtccag 300actcctacgg gaggcagcag tggggaatat tgcacaatgg gcgcaagcct gatgcagcca 360tgccgcgtgt atgaagaagg ccttcgggtt gtaaagtact ttcagcgggg aggaaggcga 420taggttaata accttgtcga ttgacgttac ccgcagaaga agcaccggct aactccgtgc 480cagcagccgc ggtaatacgg agggtgcaag cgttaatcgg aattactggg cgtaaagcgc 540acgcaggcgg tctgtcaagt cggatgtgaa atccccgggc tcaacctggg aactgcattc 600gaaactggca ggctagagtc ttgtagaggg gggtagaatt ccaggtgtag cggtgaaatg 660cgtagagatc tggaggaata ccggtggcga aggcggcccc ctggacaaag actgacgctc 720aggtgcgaaa gcgtggggag caaacaggat tagataccct ggtagtccac gccgtaaacg 780atgtcgactt ggaggttgtg cccttgaggc gtggcttccg gagctaacgc gttaagtcga 840ccgcctgggg agtacggccg caaggttaaa actcaaatga attgacgggg gcccgcacaa 900gcggtggagc atgtggttta attcgatgca acgcgaagaa ccttacctac tcttgacatc 960cagagaactt acagagatgg attggtgcct tcgggaactc tgagacaggt gctgcatggc 1020tgtcgtcagc tcgtgttgtg aaatgttggg ttaagtcccg caacgagcgc aacccttatc 1080ctttgttgcc agcggtcggc cgggaactca aaggagactg ccagtgataa actggaggaa 1140ggtggggatg acgtcaagtc atcatggccc ttacgagtag ggctacacac gtgctacaat 1200ggcgcataca aagagaagcg acctcgcgag agcaagcgga cctcataaag tgcgtcgtag 1260tccggattgg agtctgcaac tcgactccat gaagtcggaa tcgctagtaa tcgtggatca 1320gaatgccacg gtgaatacgt tcccgggcct tgtacacacc gcccgtcaca ccatgggagt 1380gggttgcaaa agaagtaggt agcttaacct tcgggagggc gctaccattt tt 1432
| Application Number | Priority Date | Filing Date | Title |
|---|---|---|---|
| KR1020090068781AKR101091151B1 (en) | 2009-07-28 | 2009-07-28 | Novel Enterobacter sp. strains and method for stimulating the growth of plant by using them |
| Application Number | Priority Date | Filing Date | Title |
|---|---|---|---|
| KR1020090068781AKR101091151B1 (en) | 2009-07-28 | 2009-07-28 | Novel Enterobacter sp. strains and method for stimulating the growth of plant by using them |
| Publication Number | Publication Date |
|---|---|
| KR20110011230A KR20110011230A (en) | 2011-02-08 |
| KR101091151B1true KR101091151B1 (en) | 2011-12-09 |
| Application Number | Title | Priority Date | Filing Date |
|---|---|---|---|
| KR1020090068781AActiveKR101091151B1 (en) | 2009-07-28 | 2009-07-28 | Novel Enterobacter sp. strains and method for stimulating the growth of plant by using them |
| Country | Link |
|---|---|
| KR (1) | KR101091151B1 (en) |
| Publication number | Priority date | Publication date | Assignee | Title |
|---|---|---|---|---|
| KR101611537B1 (en) | 2014-03-07 | 2016-04-12 | 강원대학교산학협력단 | Enterobacter ludwigii SJR3 strain promoting the growth of plants and the microbial agent containing the same |
| US10058101B2 (en) | 2013-06-26 | 2018-08-28 | Indigo Agriculture, Inc. | Methods of use of seed-origin endophyte populations |
| US10104862B2 (en) | 2013-02-05 | 2018-10-23 | University Of Saskatchewan | Endophytic microbial symbionts in plant prenatal care |
| US10212940B2 (en) | 2015-05-01 | 2019-02-26 | Indigo Agriculture, Inc. | Isolated complex endophyte compositions and methods for improved plant traits |
| US10212944B2 (en) | 2015-05-01 | 2019-02-26 | Indigo Agriculture, Inc. | Designed complex endophyte compositions and methods for improved plant traits |
| US10212911B2 (en) | 2014-06-26 | 2019-02-26 | Indigo Agriculture, Inc. | Endophytes, associated compositions, and methods of use thereof |
| US10271554B2 (en) | 2013-12-24 | 2019-04-30 | Ait Austrian Institute Of Technology Gmbh | Plants containing beneficial endophytes |
| US10306890B2 (en) | 2014-06-26 | 2019-06-04 | Ait Austrian Institute Of Technology Gmbh | Plant-endophyte combinations and uses therefor |
| US10375966B2 (en) | 2013-11-06 | 2019-08-13 | The Texas A&M University System | Fungal endophytes for improved crop yields and protection from pests |
| US10462990B2 (en) | 2014-06-20 | 2019-11-05 | The Flinders University Of South Australia | Inoculants and methods for use thereof |
| US10624351B2 (en) | 2016-12-01 | 2020-04-21 | Indigo Ag, Inc. | Modulated nutritional quality traits in seeds |
| US10640783B2 (en) | 2017-03-01 | 2020-05-05 | Indigo Ag, Inc. | Endophyte compositions and methods for improvement of plant traits |
| US10645938B2 (en) | 2017-03-01 | 2020-05-12 | Indigo Ag, Inc. | Endophyte compositions and the methods for improvement of plant traits |
| US10667523B2 (en) | 2014-12-30 | 2020-06-02 | Indigo Ag, Inc. | Seed endophytes across cultivars and species, associated compositions, and methods of use thereof |
| US10750711B2 (en) | 2015-06-08 | 2020-08-25 | Indigo Ag, Inc. | Streptomyces endophyte compositions and methods for improved agronomic traits in plants |
| US10912303B2 (en) | 2013-06-26 | 2021-02-09 | Indigo Ag, Inc. | Agricultural endophyte-plant compositions, and methods of use |
| US10932469B2 (en) | 2013-12-24 | 2021-03-02 | Ait Austrian Institute Of Technology | Method for propagating microorganisms within plant bioreactors and stably storing microorganisms within agricultural seeds |
| US11186527B2 (en) | 2012-06-22 | 2021-11-30 | Ait Austrian Institute Of Technology Gmbh | Method for producing plant seed containing endophytic micro-organisms |
| US11263707B2 (en) | 2017-08-08 | 2022-03-01 | Indigo Ag, Inc. | Machine learning in agricultural planting, growing, and harvesting contexts |
| US11589579B2 (en) | 2017-09-22 | 2023-02-28 | Biotenzz Gesellschaft Für Biotechnologie Mbh | Polymeric particles containing microorganisms |
| US11754553B2 (en) | 2013-09-04 | 2023-09-12 | Indigo Ag, Inc. | Agricultural endophyte-plant compositions, and methods of use |
| US11751515B2 (en) | 2015-12-21 | 2023-09-12 | Indigo Ag, Inc. | Endophyte compositions and methods for improvement of plant traits in plants of agronomic importance |
| US11807586B2 (en) | 2016-12-23 | 2023-11-07 | The Texas A&M University System | Fungal endophytes for improved crop yields and protection from pests |
| US11882838B2 (en) | 2017-04-27 | 2024-01-30 | The Flinders University Of South Australia | Bacterial inoculants |
| US12075786B2 (en) | 2017-09-18 | 2024-09-03 | Indigo Ag, Inc. | Markers of plant health |
| Publication number | Priority date | Publication date | Assignee | Title |
|---|---|---|---|---|
| US7743614B2 (en) | 2005-04-08 | 2010-06-29 | Bsst Llc | Thermoelectric-based heating and cooling system |
| CN104990301B (en) | 2007-05-25 | 2019-04-16 | 詹思姆公司 | Distribution formula thermoelectricity heating and cooling system and method |
| WO2010135363A2 (en) | 2009-05-18 | 2010-11-25 | Bsst Llc | Temperature control system with thermoelectric device |
| CN112644247A (en) | 2014-12-19 | 2021-04-13 | 詹思姆公司 | Thermal conditioning system and method for a vehicle area |
| US10625566B2 (en) | 2015-10-14 | 2020-04-21 | Gentherm Incorporated | Systems and methods for controlling thermal conditioning of vehicle regions |
| Title |
|---|
| JI, Y. X. & HUANG, X. D. College of Environmental Science and Engineering, Dalian Maritime University. (2008. 02. 17.)* |
| Publication number | Priority date | Publication date | Assignee | Title |
|---|---|---|---|---|
| US11186527B2 (en) | 2012-06-22 | 2021-11-30 | Ait Austrian Institute Of Technology Gmbh | Method for producing plant seed containing endophytic micro-organisms |
| US10212912B2 (en) | 2013-02-05 | 2019-02-26 | University Of Saskatchewan | Endophytic microbial symbionts in plant prenatal care |
| US11076573B2 (en) | 2013-02-05 | 2021-08-03 | University Of Saskatchewan | Endophytic microbial symbionts in plant prenatal care |
| US10104862B2 (en) | 2013-02-05 | 2018-10-23 | University Of Saskatchewan | Endophytic microbial symbionts in plant prenatal care |
| US11064673B2 (en) | 2013-02-05 | 2021-07-20 | University Of Saskatchewan | Endophytic microbial symbionts in plant prenatal care |
| US10499654B2 (en) | 2013-06-26 | 2019-12-10 | Indigo Ag, Inc. | Seed-origin endophyte populations, compositions, and methods of use |
| US10499652B2 (en) | 2013-06-26 | 2019-12-10 | Indigo Ag, Inc. | Methods of use of seed-origin endophyte populations |
| US10058101B2 (en) | 2013-06-26 | 2018-08-28 | Indigo Agriculture, Inc. | Methods of use of seed-origin endophyte populations |
| US10499653B2 (en) | 2013-06-26 | 2019-12-10 | Indigo Ag, Inc. | Methods of use of seed-origin endophyte populations |
| US10912303B2 (en) | 2013-06-26 | 2021-02-09 | Indigo Ag, Inc. | Agricultural endophyte-plant compositions, and methods of use |
| US11793202B2 (en) | 2013-06-26 | 2023-10-24 | Indigo Ag, Inc. | Methods of use of seed-origin endophyte populations |
| US10076120B2 (en) | 2013-06-26 | 2018-09-18 | Indigo Agriculture, Inc. | Seed-origin endophyte populations, compositions, and methods of use |
| US10492497B2 (en) | 2013-06-26 | 2019-12-03 | Indigo Ag, Inc. | Seed-origin endophyte populations, compositions, and methods of use |
| US11166465B2 (en) | 2013-06-26 | 2021-11-09 | Indigo Ag, Inc. | Methods of use of seed-origin endophyte populations |
| US11754553B2 (en) | 2013-09-04 | 2023-09-12 | Indigo Ag, Inc. | Agricultural endophyte-plant compositions, and methods of use |
| US10813359B2 (en) | 2013-11-06 | 2020-10-27 | The Texas A & M University System | Fungal endophytes for improved crop yields and protection from pests |
| US10375966B2 (en) | 2013-11-06 | 2019-08-13 | The Texas A&M University System | Fungal endophytes for improved crop yields and protection from pests |
| US11771090B2 (en) | 2013-11-06 | 2023-10-03 | The Texas A&M Unversity System | Fungal endophytes for improved crop yields and protection from pests |
| US11254908B2 (en) | 2013-12-24 | 2022-02-22 | Indigo Ag, Inc. | Plants containing beneficial endophytes |
| US11753618B2 (en) | 2013-12-24 | 2023-09-12 | Indigo Ag, Inc. | Method for propagating microorganisms within plant bioreactors and stably storing microorganisms within agricultural seeds |
| US10362787B2 (en) | 2013-12-24 | 2019-07-30 | Ait Austrian Institute Of Technology Gmbh | Method for propagating microorganisms within plant bioreactors and stably storing microorganisms within agricultural seeds |
| US10932469B2 (en) | 2013-12-24 | 2021-03-02 | Ait Austrian Institute Of Technology | Method for propagating microorganisms within plant bioreactors and stably storing microorganisms within agricultural seeds |
| US10271554B2 (en) | 2013-12-24 | 2019-04-30 | Ait Austrian Institute Of Technology Gmbh | Plants containing beneficial endophytes |
| KR101611537B1 (en) | 2014-03-07 | 2016-04-12 | 강원대학교산학협력단 | Enterobacter ludwigii SJR3 strain promoting the growth of plants and the microbial agent containing the same |
| US10462990B2 (en) | 2014-06-20 | 2019-11-05 | The Flinders University Of South Australia | Inoculants and methods for use thereof |
| US11445729B2 (en) | 2014-06-20 | 2022-09-20 | The Flinders University Of South Australia | Inoculants and methods for use thereof |
| US11425912B2 (en) | 2014-06-20 | 2022-08-30 | The Flinders University Of South Australia | Inoculants and methods for use thereof |
| US10306890B2 (en) | 2014-06-26 | 2019-06-04 | Ait Austrian Institute Of Technology Gmbh | Plant-endophyte combinations and uses therefor |
| US11747316B2 (en) | 2014-06-26 | 2023-09-05 | Ait Austrian Institute Of Technology Gmbh | Plant-endophyte combinations and uses therefor |
| US10212911B2 (en) | 2014-06-26 | 2019-02-26 | Indigo Agriculture, Inc. | Endophytes, associated compositions, and methods of use thereof |
| US11570993B2 (en) | 2014-06-26 | 2023-02-07 | Indigo Ag, Inc. | Endophytes, associated compositions, and methods of use |
| US11119086B2 (en) | 2014-06-26 | 2021-09-14 | Ait Austrian Institute Of Technology Gmbh | Plant-endophyte combinations and uses therefor |
| US10667523B2 (en) | 2014-12-30 | 2020-06-02 | Indigo Ag, Inc. | Seed endophytes across cultivars and species, associated compositions, and methods of use thereof |
| US11751571B2 (en) | 2015-05-01 | 2023-09-12 | Indigo Ag, Inc. | Isolated complex endophyte compositions and methods for improved plant traits |
| US11197457B2 (en) | 2015-05-01 | 2021-12-14 | Indigo Ag, Inc. | Designed complex endophyte compositions and methods for improved plant traits |
| US10212940B2 (en) | 2015-05-01 | 2019-02-26 | Indigo Agriculture, Inc. | Isolated complex endophyte compositions and methods for improved plant traits |
| US11064702B2 (en) | 2015-05-01 | 2021-07-20 | Indigo Ag, Inc. | Isolated complex endophyte compositions and methods for improved plant traits |
| US10212944B2 (en) | 2015-05-01 | 2019-02-26 | Indigo Agriculture, Inc. | Designed complex endophyte compositions and methods for improved plant traits |
| US10750711B2 (en) | 2015-06-08 | 2020-08-25 | Indigo Ag, Inc. | Streptomyces endophyte compositions and methods for improved agronomic traits in plants |
| US11819027B2 (en) | 2015-06-08 | 2023-11-21 | Indigo Ag, Inc. | Streptomyces endophyte compositions and methods for improved agronomic traits in plants |
| US11751515B2 (en) | 2015-12-21 | 2023-09-12 | Indigo Ag, Inc. | Endophyte compositions and methods for improvement of plant traits in plants of agronomic importance |
| US10624351B2 (en) | 2016-12-01 | 2020-04-21 | Indigo Ag, Inc. | Modulated nutritional quality traits in seeds |
| US11766045B2 (en) | 2016-12-01 | 2023-09-26 | Indigo Ag, Inc. | Modulated nutritional quality traits in seeds |
| US11178876B2 (en) | 2016-12-01 | 2021-11-23 | Indigo Ag, Inc. | Modulated nutritional quality traits in seeds |
| US11807586B2 (en) | 2016-12-23 | 2023-11-07 | The Texas A&M University System | Fungal endophytes for improved crop yields and protection from pests |
| US11516989B2 (en) | 2017-03-01 | 2022-12-06 | Indigo Ag, Inc. | Endophyte compositions and methods for improvement of plant traits |
| US10645938B2 (en) | 2017-03-01 | 2020-05-12 | Indigo Ag, Inc. | Endophyte compositions and the methods for improvement of plant traits |
| US10640783B2 (en) | 2017-03-01 | 2020-05-05 | Indigo Ag, Inc. | Endophyte compositions and methods for improvement of plant traits |
| US11985931B2 (en) | 2017-03-01 | 2024-05-21 | Indigo Ag, Inc. | Endophyte compositions and the methods for improvement of plant traits |
| US11882838B2 (en) | 2017-04-27 | 2024-01-30 | The Flinders University Of South Australia | Bacterial inoculants |
| US11263707B2 (en) | 2017-08-08 | 2022-03-01 | Indigo Ag, Inc. | Machine learning in agricultural planting, growing, and harvesting contexts |
| US12075786B2 (en) | 2017-09-18 | 2024-09-03 | Indigo Ag, Inc. | Markers of plant health |
| US11589579B2 (en) | 2017-09-22 | 2023-02-28 | Biotenzz Gesellschaft Für Biotechnologie Mbh | Polymeric particles containing microorganisms |
| Publication number | Publication date |
|---|---|
| KR20110011230A (en) | 2011-02-08 |
| Publication | Publication Date | Title |
|---|---|---|
| KR101091151B1 (en) | Novel Enterobacter sp. strains and method for stimulating the growth of plant by using them | |
| Shi et al. | Growth promotion effects of the endophyte Acinetobacter johnsonii strain 3-1 on sugar beet | |
| EA009126B1 (en) | Micro-organisms for the treatment of soil and process for obtaining them | |
| KR20130056585A (en) | Plant growth promotion by using bacterial strains isolated from roots of miscanthus sacchariflorus | |
| CN114934002B (en) | Novel actinomycete species and application thereof in drought resistance and growth promotion of plants | |
| KR102770476B1 (en) | Bacillus tequilensis PAMB00293 strain promoting plant growth and uses thereof | |
| Dif et al. | Potential for plant growth promotion of Kocuria arsenatis Strain ST19 on tomato under salt stress conditions | |
| CN110616171A (en) | Saline-alkali-resistant Pacific bacillus and viable bacteria preparation and application thereof | |
| CN108220210A (en) | Antagonistic Bacteria Z-18 for Controlling Cotton Verticillium Wilt and Its Application | |
| Mamarasulov et al. | Characterization, enzymatic and biochemical properties of endophytic bacterial strains of the medicinal plant Ajuga turkestanica (Rgl.) Brig (Lamiaceae) | |
| Verma et al. | Isolation and characterization of native Rhizobium from root nodules of raikia french bean growing area of Odisha | |
| KR100769360B1 (en) | Novel Bacillus subtilis S37-2 strain and microbial fertilizer containing the active ingredient | |
| CN113151082A (en) | Multifunctional soil bacterium and application thereof | |
| Khalifa et al. | Isolation and characterization of Klebsiella oxytoca from the rhizosphere of Lotus corniculatus and its biostimulating features | |
| KR102271642B1 (en) | Novel Enterobacter Strains Comprising an Effect of Promoting Plant Growth and Uses Thereof | |
| CN116970507A (en) | Separation and identification method for bacillus bailii and staphylococcus soil | |
| KR101535893B1 (en) | New microorganism Bacillus amyloliquefaciens CC110 and Microbial agent biopesticide containing the same | |
| CN111019872A (en) | Endophytic bacillus amyloliquefaciens JL-B06 and application thereof | |
| KR101098418B1 (en) | Novel Citrobacter sp. strains and method for stimulating the growth of plant by using the same | |
| KR100460633B1 (en) | The novel leclercia adecarboxylata ksj8 which solves insouble phosphate in soil | |
| KR102790382B1 (en) | Composition for promoting plant growth comprising microbial agent comprising Neobacillus drentensis CMML22-1 strain and Priestia megaterium CMML22-2 strain, or culture thereof, and manufacturing the same | |
| KR100973168B1 (en) | Pseudomonas korugata mutant strain that promotes plant growth at low temperature and method for promoting plant growth using the same | |
| Rakshit et al. | Studies on two indole acetic acid (IAA) producing endophytic bacteria from Thelypteris interrupta (Wild.) K. Iwats and their effect on seed germination | |
| KR102773772B1 (en) | Pseudomonas sp. CKDB 1010 strain with improved mupirocin production ability | |
| KR102733305B1 (en) | Novel Streptomyces sp. JC201-67 strain having algicidal activity |
| Date | Code | Title | Description |
|---|---|---|---|
| A201 | Request for examination | ||
| PA0109 | Patent application | Patent event code:PA01091R01D Comment text:Patent Application Patent event date:20090728 | |
| PA0201 | Request for examination | ||
| PG1501 | Laying open of application | ||
| E902 | Notification of reason for refusal | ||
| PE0902 | Notice of grounds for rejection | Comment text:Notification of reason for refusal Patent event date:20110414 Patent event code:PE09021S01D | |
| E701 | Decision to grant or registration of patent right | ||
| PE0701 | Decision of registration | Patent event code:PE07011S01D Comment text:Decision to Grant Registration Patent event date:20111130 | |
| GRNT | Written decision to grant | ||
| PR0701 | Registration of establishment | Comment text:Registration of Establishment Patent event date:20111201 Patent event code:PR07011E01D | |
| PR1002 | Payment of registration fee | Payment date:20111202 End annual number:3 Start annual number:1 | |
| PG1601 | Publication of registration | ||
| FPAY | Annual fee payment | Payment date:20151126 Year of fee payment:5 | |
| PR1001 | Payment of annual fee | Payment date:20151126 Start annual number:5 End annual number:5 | |
| FPAY | Annual fee payment | Payment date:20161118 Year of fee payment:18 | |
| PR1001 | Payment of annual fee | Payment date:20161118 Start annual number:6 End annual number:18 |